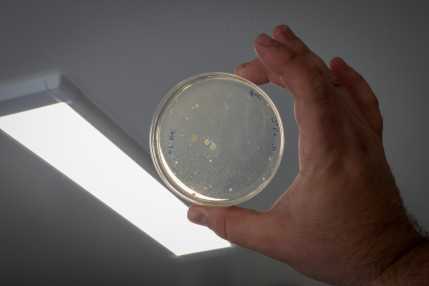

Magyar Honvédség és Pécsi Tudományegyetem közös gyakorlata: erősödik a katonai-civil együttműködés
Szerző: Tordai Kamilla | Fotó: Biró Gábor Zalán |  2025. május 8., csütörtök 13:33A Magyar Honvédség Egészségügyi Központ (MH EK) szakemberei és a Pécsi Tudományegyetem Nemzeti Virológiai Laboratóriumának kutatói ismét közös gyakorlást folytattak, az évek óta tartó szoros szakmai kapcsolat jegyében. A közös munka nemcsak a szakmai tapasztalatcserét segíti elő, hanem növeli a hazai biológiai védelmi képességek hatékonyságát is, különösen krízishelyzetekben.
Az MH EK Egészségügyi Kiképző Bázis adott otthont az egy hetes kiképzésnek, mely során a résztvevők komplex feladatokat oldottak meg: többek között mintavételt, laboratóriumi elemzéseket és különféle méréseket végeztek valós műveleti körülményekhez hasonló szimulált helyzetekben.
A gyakorláson a Pécsi Tudományegyetem kutatói aktívan részt vettek, különösen a terepi mintavételi és diagnosztikai folyamatokban, míg az MH EK Járványügyi és Tudományos Kutató Intézet a telepíthető laboratóriumi képességek mellett több speciális laborral kapcsolódott be.
A Környezet-egészségügyi Laboratórium a vizek kémiai és bakteriológiai vizsgálatát végezte, a Járványügyi Mikrobiológiai Laboratórium klasszikus mikrobiológiai vizsgálatokat folytatott, míg a Biológiai Védelmi Alosztály pedig molekuláris biológiai módszerekkel dolgozta fel a valós mintákat. Kiemelt szerepet kapott a Munka- és Sugáregészségügyi Laboratórium is, amely a különböző laboratóriumi képességek munkaegészségügyi megfelelőségét vizsgálta. Méréseik során a munkakörnyezet potenciális egészségkárosító tényezőit – például a zajt, rezgést és világítást – mérték.
A Magyar Honvédség és a Pécsi Tudományegyetem közötti szoros együttműködés nemcsak a tudományos kutatások fejlődését támogatja, hanem hozzájárulnak ahhoz is, hogy hazánk hatékonyabban reagálhasson az egészségügyi kihívásokra. A folyamatos együttműködés és a gyakorlati képzés révén mindkét intézmény készen áll arra, hogy szakértelmüket a gyakorlatban is bizonyítsák, legyen szó járványügyi helyzetről, környezeti katasztrófáról vagy más krízishelyzetről.